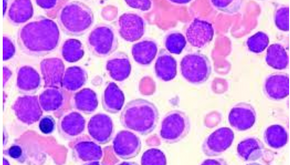

top of page
Oct 12, 20252 min read
Sep 21, 20252 min read
Sep 1, 20252 min read
Aug 21, 20252 min read
Aug 10, 20254 min read
Aug 5, 20253 min read
Jul 28, 20252 min read
Jul 17, 20252 min read
Jul 2, 20253 min read
Jun 23, 20254 min read
Jun 14, 20254 min read
Jun 8, 20254 min read
The Fractured Family: Psychosocial and Economic Burdens of Childhood Blood Cancer in Chile
Main Information: Title: The Psychosocial Burden of Families with Childhood Blood Cancer Author(s): Janya Kumar Publication Date:...
May 30, 20254 min read
May 24, 20253 min read
bottom of page